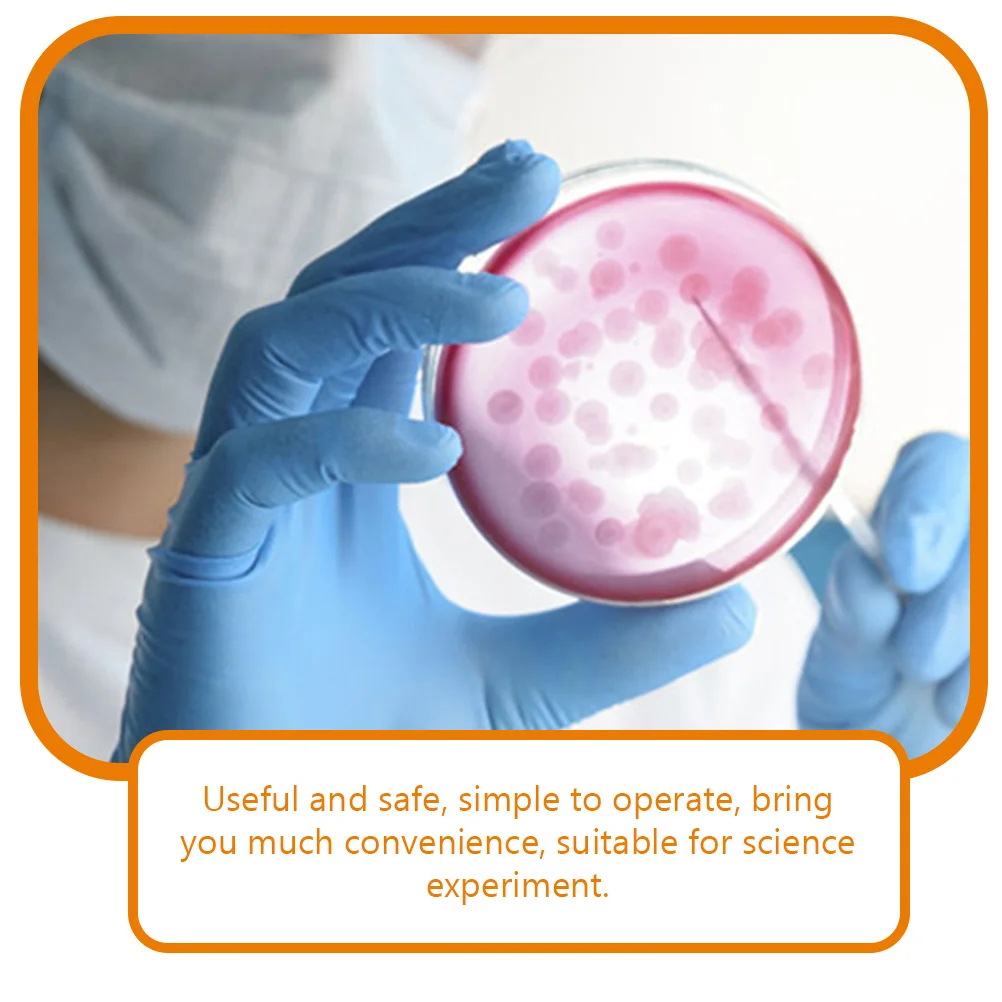

20 шт., блюда Петри для агара, для научных лабораторий
График изменения цены & курс обмена валют
Пользователи также просматривали

$2.38
Newborn Indoor Cotton Socks Bow Infant Anti Slip Baby Girl Socks Rubber Soles Baby Girl Floor Socks Spring Autumn
aliexpress.com
$9.44
Wholesale Infant Outfit Children Summer Sleeveless Strawberry Floral Tunic Tops Toddler Kids Plaid Shorts Baby Girl Flower Set
aliexpress.com
$14.05
For Jeep Renegade Camera Car Touch Screen Video Recorder Rearview mirror Dash Cam Front and Rear Camera Mirror DVR
aliexpress.com
$2.01
Перчатки женские для вождения, тонкие дышащие сетчатые митенки с защитой от УФ излучения, для занятий спортом на открытом воздухе, для сенсорных экранов, летние
aliexpress.ru
$1,188.75
Медицинское одноразовое лезвие для видеоларингоскопа, видеоларингоскоп, процедуры интубации трахеи
aliexpress.ru
$598.29
Сделано в Китае, комплект железного корпуса заднего крыла, четверть заднего крыла 2017-2023 1073677 1073678 для модели 3
aliexpress.ru
$80.90
Ретро подвесной светильник Wabi Sabi E27 для столовой, прикроватный светильник для кабинета, домашний декор, искусственная лампа, подвесной светильник, блеск
aliexpress.ru
$22.49
Аксессуары для стайлинга автомобиля для GEELY COOLRAY 2022-2024 Накладка на порог из нержавеющей стали abs
aliexpress.ru
$22.18
Классическая модель морского моллюска, модель кальмара, наутилоидея, цикл роста осьминога, экшн-фигурка, набор морских животных, детские игрушки
aliexpress.ru
$16.14
Бытовая цельная вешалка для одежды, Женская Многофункциональная вешалка для одежды, нескользящая Нескользящая вешалка для одежды
aliexpress.ru
$2.13
Tempered Film + Case For Apple watch 45mm 41mm 44mm 42mm 40mm 38mm Anti-drop protection glass for iwatch 7 6 5 4 3 SE watch cove
aliexpress.com
$50.67
Тонер-картридж для лазерного принтера CACTUS 106R03746 (12042) желтый, совместимый, 106R03746
goods.ru
$30.62
Robe Fourreau robe noire Robe semi-formelle Femme Mini robe Maille Patchwork Soirée du quotidien Rendez-vous Actif Mode Col Ras du Cou manche longue 2023 Standard Noir S M L XL XXL
miniinthebox.com
$75.58
2021 FO Motocross gear set Off Road Jersey And Pant Dirt Bike MX suit Moto Jersey Set Long Sleeve Racing Motorcycle Jersey SetsX
aliexpress.com
$6.50
Женские кроссовки с вулканизированной подошвой, Нескользящие кроссовки из сетчатого материала, повседневная спортивная обувь на платформ...
aliexpress.ru
$170.00
SWANSOFT fogger fog smoke machine 5L air humidifier ultrasonic mist maker fogger water 1200W
aliexpress.com
$17.39
Women Natural Skin Long Wallet Money Handy Bag ID Card Holder Coin Rose Embossed Retro Genuine Leather Clutch Wrist Bags Purse
aliexpress.com
$13.00
Large Soft Hand Chunky Knitted Blanket Plaids for Winter Bed Sofa Plane Thick Yarn Knitting Throw 16 Colors Sofa Cover Blankets
aliexpress.com
$17.06
Leather Casual Backpack College Backpack Men's Vintage Leather Sports Backpack Camping Hiking Travel Shoulder Bag
aliexpress.com
$8.05
5M/10M Car Door Protector Anti-Collision Strip Seal Door Edge Anti-Scratch Sticker Car Body Safety Protection Styling Moulding
aliexpress.com